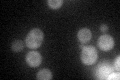
YLR387C
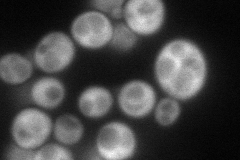
YLR387C
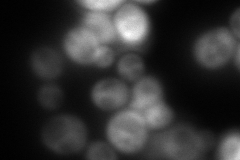
YLR387C
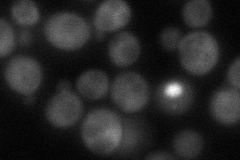
YLR387C
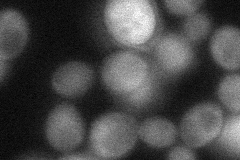
YLR387C
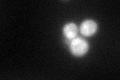
YLR387C
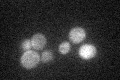
YLR387C

View description
Cytoplasmic 60S subunit biogenesis factor, associates with pre-60S particles; similar to Rei1p and shares partially redundant function in cytoplasmic 60S subunit maturation; contains dispersed C2H2 zinc finger domains
Localization:
Intensity:
Fold change:
Significance:
-
C’ GFP library in SD
cytosol44.88 -
N' NOP1pr-GFP in SD
cytosol107.681 -
N' TEF2pr-mCherry in SD
cytosol145.163 -
N' NATIVEpr-GFP in SD
cytosol54.7752 -
N' TEF2pr-VC and Cyto-VN in SD
cytosol42.8727 -
C’ GFP library in SD+DTT
cytosol46.571.03No -
C’ GFP library in SD+H2O2

cytosol62.171.38Yes -
C’ GFP library in Starvation Media
cytosol34.60.77No -
C’ GFP library on the background of Pup2-DaMP

cytosol -
C’ GFP library on the background of CCT mutant

cytosol52.53141.17025No
